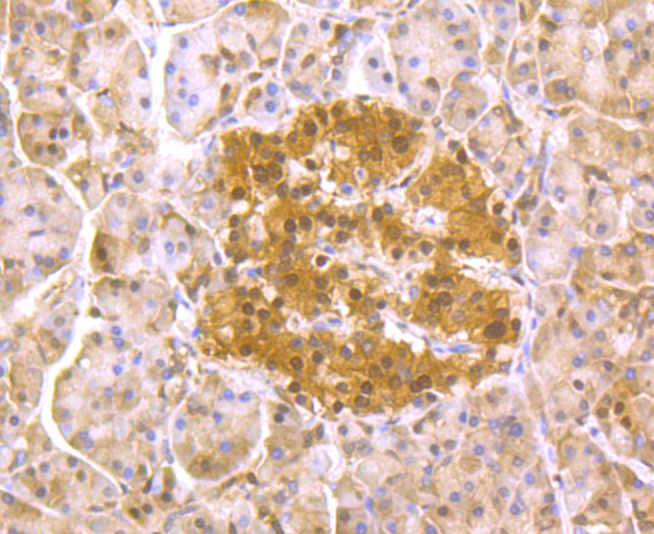

Lane 1: Jurkat Cells; Lane 2: Hela Cells; Lane 3: HepG2 Cells; Lane 4: 293 Cells; Probed with PSMA1 (10A2) Monoclonal Antibody (bsm-54170R) at 1:1000 overnight at 4°C followed by a conjugated secondary antibody for 60 minutes at 37°C.
PSMA1 Recombinant Antibody
BSM-54170R
ApplicationsFlow Cytometry, ImmunoFluorescence, Western Blot, ImmunoCytoChemistry, ImmunoHistoChemistry, ImmunoHistoChemistry Frozen, ImmunoHistoChemistry Paraffin
Product group Antibodies
TargetPSMA1
Overview
- SupplierBioss
- Product NamePSMA1 Recombinant Antibody
- Delivery Days Customer16
- ApplicationsFlow Cytometry, ImmunoFluorescence, Western Blot, ImmunoCytoChemistry, ImmunoHistoChemistry, ImmunoHistoChemistry Frozen, ImmunoHistoChemistry Paraffin
- Applications SupplierWB(WB=1:500-2000), IHC-P(IHC-P=1:50-200), IHC-F(IHC-F=1:50-200), IF(IF=1:50-200), Flow-Cyt(Flow-Cyt=1:50), ICC/IF(ICC/IF=1:50)
- CertificationResearch Use Only
- ClonalityMonoclonal
- Concentration1 ug/ul
- ConjugateUnconjugated
- Gene ID5682
- Target namePSMA1
- Target descriptionproteasome 20S subunit alpha 1
- Target synonymsHC2, HEL-S-275, NU, PROS30, proteasome subunit alpha type-1, 30 kDa prosomal protein, PROS-30, alpha-6, epididymis secretory protein Li 275, macropain subunit C2, macropain subunit nu, multicatalytic endopeptidase complex subunit C2, proteasome (prosome, macropain) subunit, alpha type, 1, proteasome component C2, proteasome nu chain, proteasome subunit alpha 1, proteasome subunit alpha 6, proteasome subunit nu, proteasome subunit, alpha-type, 1, protein P30-33K, testicular tissue protein Li 150
- HostRabbit
- IsotypeIgG
- Protein IDP25786
- Protein NameProteasome subunit alpha type-1
- Storage Instruction-20°C
- UNSPSC12352203